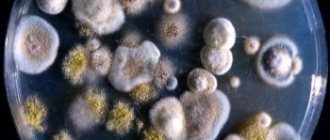

Рейтинг автора
Автор статьи
Шутофедова Ксения Юрьевна
Врач-терапевт
Написано статей
578
Об авторе
Грибковый фарингит – это заболевание глотки воспалительного характера. Развивается в результате активного размножения дрожжевидных вредных грибков из семейства Кандида. Все патологии, спровоцированные данным видом грибков, принято называть микозами, по этой причине фарингит имеет второе название – фарингомикоз глотки.
Основные причины и провоцирующие факторы
Практически во всех случаях (90%), фарингомикоза, главным фактором развития являются грибки Кандида. В остальных 10% причинами грибкового фарингита становится поражение глотки плесневыми микроорганизмами. Заболевание имеет довольно широкое распространение.
Главную роль в возникновении патологии глотки играет нарушение защитных функций организма (ослабленная иммунная система). Заболевание является частым гостем у людей страдающее от иммунодефицита либо нарушения работы эндокринной системы.
Грибковый фарингит появляется в следующих ситуациях:
- Развитие аллергической реакции.
- Поражения слизистой оболочки глотки.
- Грибковые, вирусные либо бактериальные заболевания.
- Попадание в глотку содержимого желудка.
Кроме того, есть ряд ситуаций, которые могут существенно повышать риск заражения:
- Патологии желудочно-кишечного тракта.
- Отравление разными химическими веществами.
- Регулярные переохлаждения организма.
- Длительное употребление антибактериальных средств.
Важно! Не менее важным провоцирующим фактором является: злостное употребление табака.
Основные причины и провоцирующие факторы появления болезни.
Что это за болезнь?
Как и большинство других форм фарингита, его кандидозная разновидность также отличается обширным воспалением гортани, но все же имеет ряд особенностей. В первую очередь эта болезнь способна длительный период времени находится в скрытом состоянии, постепенно наращивая свое популяционное количество, ослабляя защитную функцию иммунной системы. При это симптомы проявляются очень смазано и большинство заболевших даже не подозревают, что у них в горле развивается устойчивый к большинству медикаментов штамм грибковой инфекции.
Кандидозный фарингит в большинстве случаев поражает детей, возраст которых находится в пределах от 1 до 10 лет. В этот период их иммунная система является наиболее уязвимой и не всегда способна противостоять грибковым микроорганизмам. Новорожденным и младенцам недуг передается от матери, которая страдала хронической формой молочницы во время беременности, либо же выполняла роль носителя инфекционного возбудителя.
Взрослые люди крайне редко сталкиваются с грибковым фарингитом по той причине, что иммунитет пациента старшей возрастной группы более сильный и в 93% случаев справляется с посторонним биологическим агентом еще на стадии проникновения спор грибка в ротовой полость вместе с потоком воздуха или во время приема пищи грязными руками.
Эту болезнь не относят к категории особо опасных, которая за считанные часы или дни способна спровоцировать у пациента тяжелые последствия и осложнения, либо же стать причиной наступления инвалидности, а также летального исхода. Медленное течение недуга дает возможность пациенту своевременно заметить патологический процесс в области горла и начать медикаментозное лечение, направленное на уничтожение не только жизнеспособных микроорганизмов, но также их спор, обладающих способность распространяться по всему организму человека.
Симптомы заболевания
Грибковый фарингит, имеет типичные признаки. И при появлении можно сразу определить, что это кандидозный фарингит и обратится за помощью к врачу.
У взрослых
Самыми частыми проявлениями грибкового фарингита являются:
- Начинает болеть гортань.
- У больного наблюдается першение в горле.
- Глотка при фарингите имеет ярко выраженный красный цвет.
- Возникает кашель.
При острой форме патологии у пациента резко ухудшается общее состояние. Зачастую у человека может появляться: слабость, высокая температура тела, насморк.
Хронический кандидозный фарингит лечится довольно трудно, и требует большого терпения. При данной форме развития у человека появляется постоянное першение в горле, нередко возникает кашель преимущественно сухой. При лечении все признаки и прочие симптомы проходят практически сразу. Но вот добиться полного исцеления нелегко. Хронический грибковый фарингит является результатом частой бессонницы и нервозности.
Нередко хроническая форма заболевания является несамостоятельной патологией, то есть становиться явным признаком нарушения пищеварительной системы, поэтому пациенты часто жалуются на болевые чувства в области желудка.
У детей
Обострение острой формы кандидозного фарингита протекает аналогично, как и у взрослых. Но диагностировать развитие заболевание у детей грудного возраста довольно проблематично. Он начинает капризничать, плохо спит и ест. У детей постарше на языке может появляться белый налет, это специфический признак недуга. Грибковый фарингит у детей имеет все признаки ангина либо простудного заболевания.
В детском возрасте заболевание часто трансформируется в назофарингит. Это объясняется особенностями анатомического строения малыша. В результате этого появляется насморк.
Кроме того, у детей может появляться рефлекторный сухой приступообразный кашель, из-за першения в горле.
Приступообразный кашель.
Симптомы болезни
Существует достаточно большое количество симптомов грибкового фарингита. Не все они обязательно должны отмечаться у заболевшего взрослого или ребенка.
Симптомами фарингомикоза являются:
- болевые ощущения, возникающие при глотании;
- першение, покалывание и жжение в горле;
- отек слизистой оболочки глотки;
- белый либо желтый налет на слизистой глотки;
- резкое повышение температуры тела;
- продолжительные приступы кашля;
- болят уши, шея и челюсти;
- общее болезненное состояние;
- головная боль;
- сухость в горле.
Наличие того или иного симптома помогает определить этиологию грибковой патологии.
Например, по цвету налета, появляющегося на слизистой оболочке глотки, можно с достаточно высокой степенью уверенности определить тип грибковой инфекции, поразившей горло больного.
Так, желтый налет характерен для плесневелых грибков. Белый возникает при кандидозном фарингите. То есть в том случает если фарингит вызывается грибком кандида.
Хроническая разновидность болезни характеризуется неявными заглушенными симптомами, периодически сменяющимися резкими обострениями. Как правило, эта форма заболевания сопровождается постоянными дискомфортными ощущениями в горле больного.
Диагностика
Первым делом доктор собирает анамнез, то есть он выясняет, об образе жизни человека, что именно он принимает за лекарственные средства и как долго, в каких экологических условиях он живет. После сбора анамнеза происходит визуальный осмотр полости рта и горла, таким способом врач определяет выраженность заболевания.
Для более точной диагностики специалист назначает ряд лабораторных исследований.
Практически всегда лаборанты берут пробу с налета на миндалинах (задняя стенка гортани) – это необходимо для определения провокатора заболевания и его чувствительности к лекарственным средствам. Если доктор заподозрит, что у пациента понижена иммунная система, он посоветует пройти некоторые исследования, по результатам которых выявляется истинная причина резкого спада иммунитета.
Осмотр горла.
Лечение
Лечение кандидозного фарингита первоочерёдно направлено на подавление массивного роста грибков. Для этих целей используются:
- противогрибковые препараты для местного применения;
- противогрибковые препараты для общего применения;
- антисептики.
Антимикотики для местного применения
Препараты выпускаются в форме аэрозолей, растворов, жевательных резинок, спреев, карамели.
Основное условие при использовании местных антимикотиков – они должны максимально долго находиться в ротовой полости. При проглатывании препарата, он не будет оказывать никакого эффекта.
Антимикотики для системного применения
В случае тяжёлого течения заболевания и неэффективности применения местных препаратов, используются системные средства для приёма через рот или в уколах.
Следует отметить, что системные антимикотики, в тяжёлых случаях фарингомикозов, назначаются только врачом и принимаются под его контролем. Так как некоторые из них имеют ряд серьёзных побочных эффектов.
Антисептики
Антисептики применяются местно в виде растворов для полоскания, аэрозолей, защёчных компрессов, растворов для смазывания слизистых.
Помимо этиологического лечения, в комплексе необходимо проводить устранение и лечение общих и местных факторов, способствующих развитию микозного поражения ротовой полости:
- санация ротовой полости;
- коррекция эндокринных нарушений;
- стимуляция иммунитета.
Все эти мероприятия будут способствовать предупреждению рецидивирования кандидозных фарингитов.
Лечение грибкового фарингита
Для подавления грибкового фарингита запрещено заниматься самостоятельным лечением, и использовать народные средства. Фарингит – это довольно серьезное заболевание, может вызывать осложнения. Основой лечения грибкового фарингита – это употребление противогрибковых средств вне зависимости от своего действия (местное, общее) это могут быть:
- Пимафуцин.
- Нистатин.
- Дифлюкан.
Приведенные средства используются для перорального применения.
В качестве местного использования при показании доктором, возможно, использование:
- Ларипронт.
- Декамин.
Наносить необходимо на слизистую поверхность гортани с помощью ватной палочки. Основное вещество – декамин оказывает противогрибковое, противовирусное и противовоспалительное действие.
При стойкости грибков ко всем вышеназванным средствам, врач с большой долей вероятности назначит Амфотерицин В, вводиться внутривенно и еще Люголь на глицериновой основе. Нелишним будет полоскать горло лекарственными травами, для этой цели отлично подойдут:
- Ромашка.
- Шалфей.
- Кора дуба.
- Зверобой.
Устранить воспаление горла при фарингомикозе помогут:
- Гексорал.
- Мирамистин.
Помимо общей терапии от грибкового фарингита, нужно укреплять иммунитет при помощи иммуномодулирующих средств, нормализовать питание, использовать витаминные комплексы, принимать поливитамины.
Если терапия проходит амбулаторно (дома) нужно соблюдать строгий постельный режим, полностью находится в покое, для того, чтобы быстрее восстановить утраченные силы. В случае если фарингит спровоцирован активным развитие дисбактериоза (в результате длительного приема антибиотиков либо хронического), то в первую очередь, важно восстановить микрофлору кишечника.
Лечение грибкового фарингита:список эффективных препаратов.
Как проходит диагностика патологии
Диагностировать заболевание можно с помощью:
- осмотра пациента, сбора анамнестических данных;
- лабораторного обследования;
- методов инструментальной диагностики;
- дифференциации от похожих болезней.
Во время беседы с пациентом врач акцентирует внимание на то, какое лечение проходил больной, связано ли оно с приемом антибиотиков, глюкокортикостероидов. Для грибковой инфекции характерны рецидивы, поэтому в анамнезе это отразится.
Микотическое поражение можно выявить, исследуя мазки со слизистой пораженного органа.
Для уточнения диагноза проводят осмотр гортани с помощью оптической техники.
Обязательно проводят обследования, чтобы исключить болезни с похожими признаками. Ставится диагноз на основе гистологического исследования.
Лечение в период беременности
Грибковый фарингит у женщин в положении лечится немного по-другому, поскольку большинство лекарственных средств во время беременности запрещены. Если заболевание диагностировалось на первой стадии, то вполне будет достаточно местной терапии, дабы свести к минимальному риску неприятных последствий.
В период вынашивания плода, терапевтический эффект будет достигнут путем регулярного полоскания горла лекарственными растворами. В этом деле могут помочь:
- Настойка Прополиса.
- Раствор Фурацилина.
- Настойки на основе ромашки, шалфея.
- Раствор Хлорофиллипта.
- Слегка розовый раствор с Марганцовкой.
Чтобы во время беременности лечение было максимально эффективным нужно соблюдать следующие несложные правила:
- Процедуру полоскания гортани, необходимо делать только через тридцать минут после еды.
- Полоскать горло нужно только теплым раствором, в ином случае только сделаете хуже.
- Каждый раз нужно готовить новое лекарство.
- Полоскать нужно не менее десяти минут за раз.
- Временной промежуток между процедурами от двух до четырех часов.
- Сразу после полоскания запрещено пить и есть.
- Пить как можно больше жидкости.
- На время отказаться от жаренной и острой еды.
Как и чем проводят лечение кандидозного (грибкового) фарингита?
Для того, чтобы терапия данного вида заболевания была действительно успешной, проводится комплексное лечение всего организма с целью удаления спор грибковой инфекции. От фарингита Кандида можно избавиться с помощью препаратов следующих видов:
- Нистатин;
- Флуконазол;
- Нитамицин;
- Дифлюкан;
- Микосист.
Они выпускаются производителем в форме таблеток, а также внутримышечных инъекций. Какой именно вид медикамента применять в конкретной клинической ситуации, а также определяет его дозировку, только лечащий врач. Самостоятельная терапия недопустима, так как грибок обладает природной способностью приспосабливаться к новым лекарствам и методам лечения. После этого вывести его с поверхности слизистой оболочки горла будет еще сложнее.
Средняя продолжительность лечения фарингита грибковой этиологии составляется от 10 до 20 дней, но это с учетом, что не было осложнения болезни.
Лечение детей
Как уже было сказано у детей грудного возраста распознать развитие заболевания трудно, поскольку фарингит сильно напоминает ангину, а в особенности на первой стадии. Использовать средства для лечения детей нужно только после консультации с врачом он назначит правильный препарат и дозировку. Нужно знать, что атимикотические средства оказывают сильное лекарственное действие.
При острой форме кандидозного фарингита у детей для терапии используются:
- Медикаменты для полосканий: Фурацилин, Рокотан, Хлорофиллипт.
- Препараты для нанесения на слизистую горла: Люголь, Протаргол.
- Пастилки и леденцы для рассасывания: Фарингосепт, Лизобакт, Септефрил,Имудон, Стрепсилс.
- Аэрозоли для орошения выпаленного горла: Йокс, Мирамистин, Каметон, Тантум верде.
- Антибиотики для подавления патогенной микрофлоры: Афлубин, Лаферобион, Виферон.
- Растворы для проведения ингаляций: Десакан, Сода-буфер.
- Жаропонижающие средства используются при температуре выше 38 градусов.
Средства народной медицины
- Полоскание горла теплом отварам из лекарственных трав. Самыми эффективными считаются: шалфей, календула, ромашка.
- Ингаляции на основе трав хорошо подойдут: зверобой, сосна, ромашка, эвкалипт.
- Регулярное полоскание горла растворам их соды и соли. Для приготовления необходимо взять по одной чайной ложке каждого компонента и перемешать с 400 миллилитрами теплой воды, после подождать пока частички растворятся и полоскать горло каждые два часа.
- Хорошо растереть шею, спину и грудь камфорным маслом, небольшое количество масла нанести на чистую марлю и приложить к шеи с таким компрессом спать всю ночь.
- Сливочное масло лучше всего домашнее перемешать с поваренной солью, намазать горло и сверху укутать полиэтиленовой плёнкой, так это лекарство подойдет для смазывания миндалин.
- Свежие листья алоэ растереть до образования кашицы, получившуюся смесь перемешать с оливковым маслом и оставить в покое на пять суток. После приготовления аккуратно мазать горло два раза в сутки.
- Взять листья подорожника только свежие. Хорошо их помыть, порезать и добавить к нему мед и варить на медленном огне двадцать минут. Затем употреблять по чайной ложке три раза в день.
- Для этого рецепта необходимо сварить мед с чесноком. Употреблять по два раза в день через каждый час.
Методы лечения детей.
Фарингомикоз: лечение
При такой форме фарингита любые народные методы, а также полоскания и ингаляции – бессильны.
Действенным средством являются только современные противогрибковые препараты.
При этом результативное лечение возможно только в условиях стационара, а курс медикаментозной терапии длится от 10 дней до двух недель.
Лечение выполняется одновременно по двум направлениям: устранение патогенной микрофлоры и укрепление иммунной системы, которая должна самостоятельно бороться с вредоносными микроорганизмами.
Помните! Для этого применяются в комплексе антисептические, противогрибковые, иммуномодулирующие и антибиотические препараты.
Наиболее распространенными являются следующие лекарства:
- натамицин;
- нистатин;
- флуконазол;
- кетоконазол;
- леворин;
- тербинафин.
Помимо этих противогрибковых препаратов и иммуностимуляторов необходимо пройти курс лечения, в который входят нормализующие микрофлору средства, среди которых – аципол, линекс, вобэнзим, бактисубтил.
Дополнительно можно применять местные препараты в виде спреев гексорал или мирамистин, также благотворный эффект может оказать раствор люголя.
Полоскания травяными отварами в терапевтическом плане пользы не принесут.
Но такой метод может помочь устранить отечности и поспособствовать восстановлению очищенной слизистой оболочки.
Если антигрибковый курс длится до двух недель, то иммуномодуляторы требуется принимать в течение двух месяцев.
При этом необходимо исключить из рациона пищу с повышенным количеством углеводов и в целом скорректировать свой рацион.
Физиотерапия
Физиотерапевтические процедуры хорошо устраняют воспаление и отек, помогает наладить работу кровообращения и укрепить защитные функции организма. Эффективными физиотерапевтическими средствами являются:
- УВЧ на область горла.
- Проведение ингаляций с противовоспалительным эффектом.
- Лазерная терапия.
- Аэротерапии.
- КУФ-облучение.
- Электрофорез.
- Талассотерапия.
УВЧ на область горла.
Разновидность грибкового фарингита: хронический и острый
Воспалительный процесс провоцирует в горле болезненные ощущения.
Клиническое развитие патологии включает в себя острую и хроническую форму. Обе формы характеризуются образованием воспалительных пузырьков на дальней стенке слизистой глотки, миндалинах. Течение патологии чаще носит хронический характер, обостряясь несколько раз в году. Острый фарингит часто трансформируется в хроническую форму. Способствует переходу неграмотные диагностические процедуры и некомпетентное назначение терапии.
Острая форма проявляется общим ухудшением самочувствия, появляется вялость, температурные показатели тела постепенно поднимаются. Развиваясь, болезнь может распространиться и вызвать ринит. Хронический вид проявляется не так выражено. Сопровождаются першением и покашливанием, общего недомогания не фиксируется. Однако постоянные покашливания могут вызвать раздражения слизистой и доставить неприятные ощущения.
Лечение фарингита народными средствами
Лечение фарингита народными средствами, которые являются достаточно эффективными и могут использоваться даже в роли основной терапии.
Фарингит можно вылечить, используя следующие способы народной медицины:
- Полоскание при помощи теплого отвара лекарственных растений, которые обладают антибактериальным действием (ромашка, шалфей, календула);
- Ингаляции парами отваров таких лекарственных трав, как ромашка, эвкалипт, шишки сосны и зверобой;
- Полоскание горло с использованием теплого раствора соды и соли — по ½ маленькой ложки соды и соли на 250 мл теплой кипяченой воды;
- Продукты пчеловодства в роли общеукрепляющего средства. Для этих целей необходимо полоскать горло раствором прополиса, употреблять пыльцу, мед;
- Согревающее питье, предполагающее прием горячего чая с лимоном или из ромашки аптечной, теплого молока с медом;
- Укрепление иммунитета с использованием настойки из спирта и листьев эхинацеи пурпурной.
Представленные народные средства, при помощи которых можно вылечить фарингит, хороши тем, что обладают мягким воздействием на организм, повышают общую и местную сопротивляемость. Но использовать продукты пчеловодства и лекарственные растения разрешено только тем людям, кто не страдает на аллергическую реакцию.
Причины и виды
Появление грибка рода Кандида в ротовой полости не такое уж редкое явление как для детей, так и для взрослых, однако в основном он локализуется на небе, щеках и языке. При неблагоприятных условиях он возникает на небных дужках, небных миндалинах, глотке, а способствуют этому следующие факторы:
- длительное применение препаратов-антибиотиков;
- иммунодефицит;
- дисбактериоз;
- молочница;
- переохлаждение;
- гормональный дисбаланс;
- переутомление, стресс;
- неправильное ношение зубных протезов;
- злоупотребление кондитерскими изделиями;
- злоупотребление алкогольными напитками и табачными изделиями;
- химиотерапия, облучения различных видов;
- эндокринные нарушения;
- гастриты, изжога, сопровождающиеся выбросом кислоты в полость глотки.
Различные повреждения глотки и гортани приводят к воспалениям и эрозиям, а это, в свою очередь, благодатная почва для развития микоза. Так, повредить горло можно пищей с острыми краями, а также вследствие термического или химического ожога.
Кроме того, после длительных или постоянных болезней (ОРВИ, грипп) грибковые заболевания глотки более вероятны.
В норме в организме человека присутствует различная микрофлора, включая грибки. Однако из-за вышеперечисленных причин она развивается сильнее, чем нужно, что и вызывает грибковый фарингит. Фарингомикоз может иметь острую или хроническую стадию.
Кроме того, если поражена не только глотка, но и составляющие полости рта и горла, может возникнуть:
- стоматит,
- глоссит,
- гингивит,
- тонзиллит.
Грибковое поражение слизистой полости рта — сопутствующее проявление
По клинико-морфологическим признакам грибковый фарингит подразделяется на следующие виды:
- Псевдомембранозный. Для него характерен белый творожистый налет, который располагается на красной и отекшей слизистой, возможны кровотечения.
- Катаральный. Возникают обширные эритемы (красные пятна, появляющиеся из-за расширения капилляров), при этом наблюдается жжение и сухость слизистой.
- Гиперпластический. Возникают белые бляшки и пятна, которые с трудом отделяются от слизистой.
- Эрозивно-язвенный. В полости рта на месте бляшек образуются кровоточащие очаги.
Степень выраженности фарингомикоза зависит от протяженности заболевания и сопутствующих факторов.
Лечение заболевания во время беременности
Любая болезнь во время беременности является неприятным, а также приносит будущей маме множество неудобств. Это связано с тем, что в период вынашивания ребенка многие эффективные методы лечения не доступны, ведь могут отрицательно повлиять на развитие плода. Это же и касается лечения такого безобидного недуга, как фарингит.
Осуществляя лечение фарингита при беременности, следует придерживаться нескольких правил. Основные среди них:
- Больное горло должно находиться в покое, чтобы не напрягался голосовой аппарат, лучше не разговаривать, а, в случае необходимости, делать это шепотом и редко,
- Периодическое полоскание горла,
- Прием необходимых лекарств;
- Теплое обильное питье. Для этих целей лучше применять щелочные (минеральная вода без газа, молоко) или витаминосодержащие, напитки (чай с лимоном, клюквенный морс).
- Убрать из рациона соленые, острые и копченые блюда.
- Полоскать горло. Для этого использовать отвары и настои лекарственных трав: календула, ромашка, шалфей, подорожник. Разрешается использовать готовые настойки, при использовании которых необходимо разводить водой. В роли таких настоев могут выступать: Ромазулан, Ротокан и другие. Для полоскания горла при фарингите еще применяют раствор Фурацилина. Хорошо справляются с задачей спреи и аэрозоли, например, Гексорал.
Особенности лечения у детей
Фарингомикоз у детей лечат в соответствии с теми же принципами, что и у взрослых. Главное – не забывать осматривать горло ребенка на наличие пленок, когда он жалуется на першение и сухость. Обычно для излечения ребенка достаточно применения местных средств. Хорошо работают таблетки для рассасывания с широким антисептическим действием Фарингосепт. Также у детей эффективен спрей Орасепт, который помимо бактерий уничтожает грибки рода кандида.
Советы доктора Комаровского
В лечении фарингитов разного происхождения у ребенка доктор Комаровский советует придерживаться такого алгоритма:
- Сдать анализ – мазок со стенок горла, чтобы определить, является ли грибок причиной болезни.
- Обязательно полоскать горло шалфеем, ромашкой или зверобоем.
- Проветривать комнату.
- Применять антисептик в виде спрея Орасепт, который обладает противогрибковыми свойствами.
Доктор Комаровский рассказывает, что такое грибковые инфекции и как с ними бороться